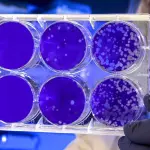
Monkeypox, il vaiolo delle scimmie non sarà una pandemia

Ultime dal web

Ci sono quattro civiltà ostili nella Via Lattea
Redazione - 06 giu 2022

Cruise: L'auto del futuro arriva a San Francisco
Redazione - 04 giu 2022

Brian Cox rivela: Vi dico dove sono gli alieni
Redazione - 25 mag 2022

Mancano due giorni all'enorme asteroide 7335
Redazione - 25 mag 2022